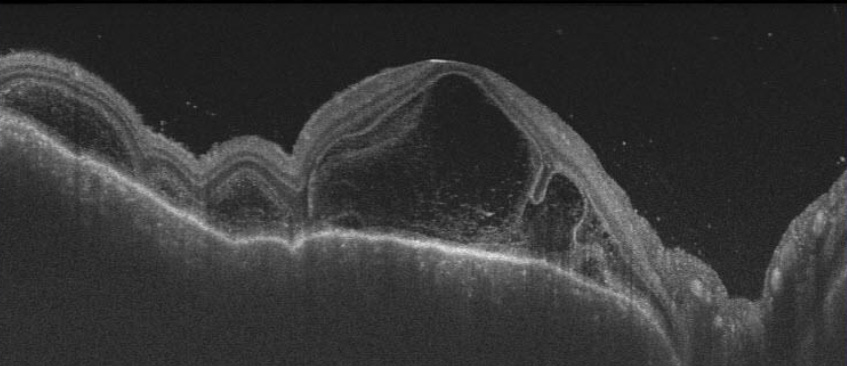
光干渉断層計の画像（フォークト・小柳・原田病）

専門外来のご紹介

Message最先端医療と地域連携で、
あなたの“見える”を守ります
愛媛大学医学部眼科学教室では、角膜、網膜、緑内障、ぶどう膜炎、斜視・弱視、涙道・眼形成など幅広い専門外来を設置し、最先端の検査機器と高度な外科・内科治療を提供しています。患者の症状や状態に応じた個別治療を行い、地域医療機関とも連携しながら、視機能の維持・改善と生活の質向上を目指しています。
cornea角膜
当科における角膜外来診療の特色は、多くの角膜専門医師が、あらゆる角膜疾患について専門治療を行うことです。角膜について先天異常、各種ジストロフィー、変性症、感染症、外傷性疾患、重症ドライアイ及び原因不明の角膜内皮障害などあらゆる診療分野をカバーしています。
角膜診療にあたって、当院では最先端検査機械が揃っています。例えば、レーザー共焦点顕微鏡(HRT-II RCM、図1)は非侵襲的に眼表面を細胞レベルで観察することができ病態解明に大変役に立ちます。また、CASIA SS-1000前眼部光干渉断層計(AS-OCT)は角膜以外、前房、隅角、虹彩など前眼部のあらゆる組織の形態を三次元で非侵襲的に検査することができます。特に、角膜手術の際に術前、術後のフラップ厚の測定、角膜形状は表面及び裏面の評価もでき画期的な貢献を果たしています(図2)。
当科角膜外来では内科的治療(点眼、点滴など)と外科的治療(手術)をバランスよく、患者一人ひとりの病状病態にあわせて、最善の医療を提供しより良いQOV(quality of vision)を目指して毎日鋭意前進しております。
図1. 共焦点レーザー顕微鏡検査

HRTII-RCM

角膜上皮像
図2. 前眼部OCT検査

CASIA SS-1000

前房、隅角解析例
担当医表
| 月曜日 | 火曜日 | 水曜日 | 木曜日 | 金曜日 |
|---|---|---|---|---|
| 白石 敦 竹澤 由起 | 白石 敦 坂根 由梨 竹澤 由起 鳥山 浩二 井上 英紀 | 坂根 由梨 鳥山 浩二 | 井上 英紀 |
retina網膜
網膜剥離、黄斑円孔、黄斑前膜、硝子体出血など外科手術を要するものから加齢黄斑変性、糖尿病網膜症、網膜静脈閉塞症、中心性漿液性網脈絡膜症などレーザー治療、薬物治療が中心になる眼底疾患まで幅広く対応しています。
眼底疾患の診断機器としては光干渉断層計(OCT)を3種類、蛍光眼底検査機器を2種類導入しており、疾患に合わせて使い分けています。加齢黄斑変性の場合、治療中に病変の再発を生じることも多いですが、自覚的に変化がなく、肉眼的にも分からないような微細な変化がOCTを使うと早い時期に検出できることが多く、診療上欠かせない診断機器になっています。蛍光眼底検査は加齢黄斑変性だけでなく、ほとんどの網膜の疾患の診断で必要な検査ですが、当科では黄斑部(網膜の中央部)を高解像度でみる機種と、眼底全体を造影できる機種の2種類を導入しています。
図1. HRA2-Spectoralis (Heidelberg Engineering)でみる加齢黄斑変性の造影像

HRA2は1台で2種類の蛍光眼底撮影(網膜中心(上左)、網膜下中心(上右)の造影)、OCT(下右)の高解像度撮影が可能です。
ポリープ状脈絡膜血管症というタイプの加齢黄斑変性で、網膜下にぶどうの房状のポリープ病巣(上右)、それによる滲出病変(上左)が造影されています。OCTでは網膜下から盛り上がっている滲出病変がわかります(下)。
図2. OCT-2000 (TOPCON)でみる加齢黄斑変性の治療経過

治療を開始してからの経過を見ていくと、画面左側にあった網膜下の滲出病変が、時間の経過とともに徐々に縮小し、明らかに減ってきている様子が確認できます。これは治療の効果が着実に現れていることを示しています。
外科的治療
最新の硝子体手術装置を導入しており、疾患によっては手術の切り口がより小さい小切開手術により術後のより早い視機能回復、社会復帰を目指しています。網膜剥離や黄斑円孔などの眼底疾患では手術後に眼内にガスや空気を注入してうつぶせの姿勢を保つことが治療上必要ですが、期間がなるべく短くなるように工夫しています。
内科的治療
加齢黄斑変性に対する抗VEGF製剤の硝子体投与を2009年より開始しています。
また以前からの治療法である光線力学療法(光感受性物質を用いたレーザー治療)、あるいは光線力学療法と抗VEGF製剤とを併用するのがよい場合もあり、個々の状態に応じて治療方針を決めています。抗VEGF製剤治療は通院での治療が可能ですが、月に2-3回の通院が継続的に必要になるため、遠方の患者さんについては地元の眼科との連携により、できるだけ通院の負担を減らすようにしています。
レーザー治療
糖尿病網膜症の治療の中心になるのがレーザー治療ですが、当院ではマルチパターンレーザーを導入しており、治療時の痛みや、1回の治療にかかる時間が以前より軽減されています。このほか加齢黄斑変性に対するレーザー治療として、上記の光線力学療法を行っています。光感受性物質(ベルテポルフィン)を静脈注射した後に低出力のレーザーを眼底に照射して、加齢黄斑変性の病巣を潰す治療ですが、このため治療後に光感受性物質が体内から抜けるまでの数日間は遮光が必要になりますので、当科では入院で行っています。

一回の撮影で200°の画角(網膜全体の約80%)という広範囲の眼底像が得られます。撮影時間も0.2〜0.3秒でさらに無散瞳で撮影出来るため従来の眼底カメラと比較して撮影にかかる負担が少なくなります。

図・・・網膜静脈分枝閉塞症の眼底写真です。眼底造影写真も撮影可能で病変領域の血管拡張や造影剤の血管外漏出が確認されます。
担当医表
| 月曜日 | 火曜日 | 水曜日 | 木曜日 | 金曜日 |
|---|---|---|---|---|
| 池川 泰民 | 立花 亮祐 | 小林 武史 立花 亮祐 | 小林 武史 |
glaucoma緑内障
緑内障とは
緑内障は我が国の中途失明原因の第1位です。
緑内障とは眼から脳につながる視神経に障害がおこり、視力、視野障害を引き起こしてしまう疾患です。2000年代初頭に我が国で行われた疫学調査において、40歳以上の約20人に1人は緑内障であることがわかっており、さらに、2022年の報告では7.6%と報告されています。
眼球にはその形態を保持するために一定の圧力が必要で、それを眼圧といいます。眼圧の正常値は21mmHg 未満です。眼圧が高ければ視神経を圧迫する力が強くなり、視神経を障害する危険性が高くなります。しかし、眼圧が正常値でも安心はできません。日本人に最も多いとされる正常眼圧緑内障は、眼圧が正常範囲内にありながら視野障害が進行することが特徴です。したがって、眼圧値が高い、低いのみで緑内障であるかどうかの判断はできません。
緑内障の初期には多くの場合、自覚症状はなく、気付かない間に進行し自覚症状が出たころには重症化している可能性があります。また、一度進行した視力、視野障害の改善は困難です。しかし、早期に発見し、適切な時期に治療を開始できると、進行を抑制できる可能性が高くなります。実際にきちんと治療されている緑内障患者さんのほとんどは失明には至っていません。
緑内障の検査
当院では、眼圧検査、視野検査、眼底検査といった一般的な検査に加え、最新の光干渉断層計(OCT)を用いた検査もおこなっています。OCTとは、非侵襲的に眼底に弱い赤外光を当て、その反射を解析することで網膜の断層画像を得ることができる器械です。従来の検査では発見困難であった微細な変化をとらえることが可能で、緑内障によって障害された視神経線維層と細胞層の異常をより早期に発見できます。視野検査で異常が出ていないごく早期の緑内障も発見できるため、積極的に検査を行っています。(図1)
眼圧検査は、空気眼圧計、ゴールドマン眼圧計、トノペンR、アイケアRといった複数の眼圧計があり、個々に合わせて最も信頼できる方法で眼圧測定を行っています。
視野検査は主にハンフリー視野検査とゴールドマン視野検査の2種類で行っており、視野障害の状態や、進行の状況に応じて行っています。(図2)
緑内障の治療
緑内障は眼圧を十分に下降させることによって多くの症例の進行を抑制できることがわかっています。しかしながら、治療を行っても障害された視力、視野が改善することは困難で、治療の目標は残っている視機能の維持にあります。当院では薬物(点眼、内服)治療、レーザー治療、手術治療をおこなっています。目標となる眼圧を設定して、一般的には薬物治療から開始します。現在緑内障治療薬には作用機序の異なる多くの種類があり、まずは単剤から治療を開始し、状態によって点眼の追加や種類の変更などを行い、目標眼圧の達成を目指します。薬物治療で目標眼圧が達成できない場合や、視野障害が進行する場合に必要に応じてレーザー治療や手術治療を選択しますが、近年は早期のレーザー治療や手術介入の有効性も見直されています。
手術治療においては、従来からの線維柱帯切除術に加えて、手術用デバイスを用いた濾過(チューブシャント)手術(アーメド™緑内障バルブ、プリザーフロ®マイクロシャント、エクスプレス™ など)や、線維柱帯切開術以外の低侵襲緑内障手術(MIGS:Minimally invasive glaucoma surgery)( iStent inject® W、Kahook Dual Blade、Hydrus ® マイクロステント等)も増加し、術式の多様化が進んでいます。当院では緑内障の病型や病期、眼圧や術後管理などを総合的に判断して、患者様に最適と考えられる治療をご提案しています。
図1. 光干渉断層計

最新のOCTで診断された極早期の緑内障
右眼(むかって左側)は極初期視野障害期
左眼(向かって右側)は前視野障害期
図2. ハンフリー視野検査

黒くなった部分に視野障害があります。左から正常、中期視野障害、末期視野障害で黒い部分が増加しています。
担当医表
| 月曜日 | 火曜日 | 水曜日 | 木曜日 | 金曜日 |
|---|---|---|---|---|
| 溝上 志朗(午後予約制) 奥野 周蔵 | 溝上 志朗 浪口 孝治 奥野 周蔵 | 浪口 孝治 |
uveitisぶどう膜炎
ぶどう膜炎とは、虹彩・毛様体・脈絡膜を中心に、眼のさまざまな部位に炎症が起こる病気です。原因は、全身の自己免疫性疾患や感染症など、多岐にわたります。そのため、詳しい検査を行って原因を調べることが大切です。国内のぶどう膜炎全国調査において、原因疾患の1位はサルコイドーシス、2位はフォークト・小柳・原田病、3位はヘルペス性虹彩炎という疾患です。ただし、原因が特定できないぶどう膜炎も存在します。そのような場合でも、検査結果をもとに最適な治療法を選択していきます。
ぶどう膜炎の症状
眼の充血、痛み、かすみ、飛蚊症、視力低下などの症状があらわれます。症状がいつから出ているのか、片眼か両眼か、改善しているか悪化しているか、などを問診します。
ぶどう膜炎の検査
眼の中を隅々まで診察し、ゴニオスコープ、広角眼底カメラ、光干渉断層計(前眼部・後眼部)、蛍光眼底造影検査などの検査を行います。また血液検査やレントゲン検査による全身の精査も行います。必要に応じて、眼内の病原体を検出するために前房水を採取する場合があります。
ぶどう膜炎の治療
副腎皮質ステロイド薬の点眼を中心として、状態に応じてステロイドの眼注射や内服を行います。全身疾患が原因の場合には、内科と連携し、免疫抑制剤や生物学的製剤を用いることがあります。感染症が原因である場合には、それぞれの病原体に対する治療薬を使用します。
図1. 光干渉断層計の画像(フォークト・小柳・原田病)
図2. 広角眼底カメラと蛍光眼底造影検査の画像(サルコイドーシス)
担当医表
| 月曜日 | 火曜日 | 水曜日 | 木曜日 | 金曜日 |
|---|---|---|---|---|
| 平松 友佳子 | 平松 友佳子 |
strabismus/amblyopia斜視・弱視
斜視
斜視とは両眼の視線が正しく目標に合致せず、一眼の視線が目標とは別の方向へ向かっている状態です。内斜視や外斜視といった水平斜視、上下にずれる上下斜視、ドアノブを回す方向に眼位がずれる回旋斜視といったものがあります。
斜視の原因としては先天性(生まれつき)、外眼筋異常、神経麻痺、頭蓋内疾患、視力不良、屈折調節の異常などがあります。具体的には生後まもなくからみられる乳児内斜視、脳腫瘍や脳梗塞に伴う斜視などがあり、また調節性内斜視といって眼鏡をかけて遠視の矯正をすると斜視が改善するものもあります。ときどき外斜視になる間欠性外斜視という病気もあります。
斜視になるとも複視(ものが二重に見えること)が出現したり、遠近感がなくなって、車の運転など日常生活に支障をきたします。また眼線のずれが大きい場合には、整容面でも不利になります。さらに視覚感受性期にあるこどもの場合弱視を発症する可能性もあります。
斜視の症状や原因は患者さんによって異なるので、それぞれの患者さんに合わせた治療が必要となります。斜視の治療として当院では眼鏡作成、ボツリヌス毒素の外眼筋への投与、手術を行っています。
弱視
医学的弱視は機能弱視とよばれることもありますが、視力の発達の感受性期に両眼同時に網膜に適切な視覚刺激を受け取ることができなかったために視力の発達が止まったり遅れたりすることを言います。感受性期は生後1か月から生後18か月までは非常に高く、その後徐々に減衰し8歳くらいまで残存するといわれていります。つまり弱視の治療は大人になってから行ったのでは効果を得ることが困難で、なるべく低年齢のうちに開始することが重要です。
原因としては高度な乱視や遠視などの存在、屈折の左右差、斜視、また形態覚遮断弱視といって白内障や眼瞼下垂などが原因となることもあります。治療には適切な屈折矯正(眼鏡やコンタクトレンズの使用)が必要となります。従来の検査機器では検査が困難である子にも、スポットビジョンスクリーナー(図1)、手持ち型のレフケラトメーター(図2)、検影法を駆使して適切な眼鏡処方を行うように努めています。低年齢のこどもたちの視機能を評価するための道具(図3)もそろえています。視力に左右差がある子については健眼遮閉と言って、わざと視力の良い方の眼をアイパッチで隠して、視力の悪い方の眼を使用させるような訓練を指示します。
斜視弱視外来にはこどもだけでなく、若い方からご高齢の方まで成人の患者さんも多くいらっしゃいます。何か気になることや心配なことなどありましたらご相談ください。
図1. スポットビジョンスクリーナー

スポットビジョンスクリーナー(ウェルチ・アレン)。簡単にかつ短時間で屈折異常や斜視のスクリーニングが可能。
図2. 手持ち型のレフケラトメーター

レチノマックス K-plus 5(ライト製作所)。顎台に顔を載せずに屈折検査を行うことが可能。
図3. 低年齢のこどもたちの視機能を評価するための道具

向かって左側がテラーアキュイティカード(プレシジョンビジョン)。乳幼児が無地の面より縞模様を好んで見る傾向があるという特性を利用して視力を評価する。右側は両眼視機能を評価する道具。
担当医表
| 月曜日 | 火曜日 | 水曜日 | 木曜日 | 金曜日 |
|---|---|---|---|---|
| 奥嶋 奈美 | 飯森 宏仁 | 飯森 宏仁 奥嶋 奈美 |
lacrimal涙道・眼形成
涙道
涙液は常時、涙腺から分泌されて様々な機能を発揮して眼の表面を健常に保ち、涙道から排出されます。涙道が閉塞すると、眼表面の涙液量 が多くなるだけでなく、眼表面や涙道に老廃物や細菌が貯留し、眼表面に異常が起こり、様々な症状を訴えます。流涙(涙がこぼれる)や眼 脂(目やにが出る)が代表的な症状で、涙道閉塞の患者様は常に涙をふく、眼脂を気にするようになり、日常生活の質:Quality of Life (QOL) に多大な影響を及ぼします。また眼表面の涙が多くなると、ぼやけて見えにくいと感じるようになり、日常生活の見え方の質: Quality of Vision (QOV)を低下させることが明らかとなり、涙道疾患の治療の重要性が認識されるようになりました。また、眼表面や涙道 に細菌が異常増殖すると、角膜が溶けて穴が開いたり(角膜穿孔)(図1)、涙道に感染を起こして強い痛みや腫れが生じ(急性涙囊炎) (図2)、最悪失明することがあります。たかが「涙がこぼれる、目やにが出る」だけと治療せずに放置すると、重篤な状態に進行する可能 性があります。
当科では問診・視診・前眼部OCT検査(図3)、細隙灯顕微鏡検査・蛍光色素消失試験・触診・涙液分泌機能検査(シルマー試験)・涙管通 水検査・培養検査・涙道内視鏡検査(図4)・鼻内視鏡検査・CT検査、涙道造影検査を行い、涙道疾患の診断や病状評価を詳細に行い、治療方針の決定に役立てています。
涙道閉塞の治療は大きく涙道内腔再建術と涙囊鼻腔吻合術に分けられます。涙道内腔再建術は、入院が不要で手術時間が10分程度と短く、骨の切除や皮膚・粘膜の切開が不要で、合併症もほとんどない、低侵襲で安全な術式です。ただ治療成績がもう一方の治療と比較すると劣るという欠点があります。涙囊鼻腔吻合術は、入院が必要で手術時間が30-60分必要で、鼻出血や髄液漏といった合併症が起こることがある、侵襲のやや大きな術式です。しかし治療成績が非常に優れているため、世界的な標準治療となっています。当院では術前に詳細な病状評価を行い、病状と患者様のご希望に沿って治療方針を選択しております。
図1. 涙道閉塞により角膜穿孔に至った症例

角膜中央の窪み(左)
角膜の一部が極端に薄くなっています。(右)
図2. 左急性涙囊炎

左の目と鼻の間が強く腫れています。
図3. 前眼部OCTを用いた涙液の断面図撮影
図4. 涙道内視鏡

現在、FiberTech(左)、町田製作所(中央)の2社から涙道内視鏡が販売されています。 涙道内視鏡による涙道内の観察(右)
担当医表
| 月曜日 | 火曜日 | 水曜日 | 木曜日 | 金曜日 |
|---|---|---|---|---|
| 白石 敦 鎌尾 知行 | 三谷 亜里沙 | 鎌尾 知行 三谷 亜里沙 |
眼形成
眼球は、眼瞼などの眼球付属器と適切に相互作用することで、良好な視機能を発揮します。我々の教室では、高齢化に伴い有病率が高まっている眼瞼下垂や眼瞼内反症の手術を中心に、治療を行なっております。
眼瞼下垂は先天性と後天性に分類されます。いずれもまぶたが下がって見にくくなる、視界が狭くなるといった視機能に影響します。そのほかにも頭痛や肩こり、眼精疲労といった症状に悩まされます。先天性の場合、視機能発達が障害され、弱視になる可能性が34.2%という報告もあり、適切なタイミングで治療が必要になります。治療は手術しかなく、病状に応じて挙筋腱膜前転術・挙筋群短縮術・前頭筋吊り上げ術を選択しております(図5)。
眼瞼内反症は、小児に起こる先天睫毛内反症と成人に起こる退行性眼瞼内反症がほとんどです。いずれも目やに、ゴロゴロ感、眼の痛み、まぶしさ(羞明)といった症状を自覚します。先天性の場合、視機能発達が障害され、弱視になる可能性があり、適切なタイミングで治療が必要になります。治療は手術しかなく、病状に応じて埋没法・切開法・Kakizaki法・Lateral tarsal strip procedure・Transcanthal canthopexyを選択しております(図6)。
図5. 右上眼瞼下垂術前後

術前(左)
術後 2ヶ月(右)
図6. 両先天性下眼瞼睫毛内反症術前後

術前(左)
術後 2週間(右)
右目は睫毛内反症により角膜が高度に障害され、強い痛み、まぶしさを感じ、術前は目がうまく開けられなかったが、手術により目が開けられるようになっている。
担当医表
| 月曜日 | 火曜日 | 水曜日 | 木曜日 | 金曜日 |
|---|---|---|---|---|
| 鎌尾 知行 | 三谷 亜里沙 | 鎌尾 知行 三谷 亜里沙 |
お問い合わせ
見学をご希望の方、またはお問い合わせの方は、こちらからお手続きください。
Contact